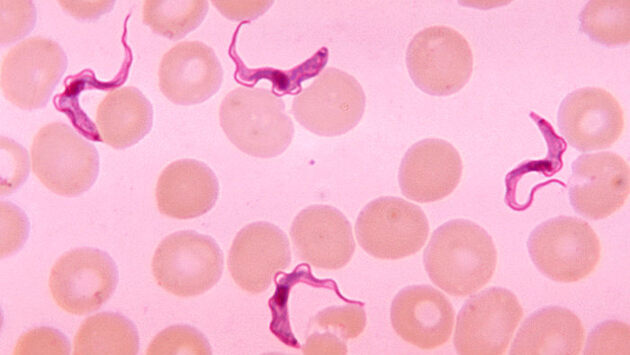
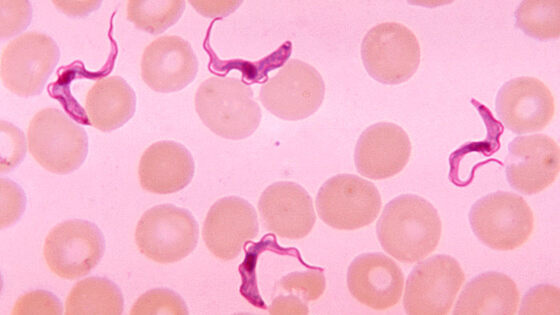

Сонная болезнь поражает циркадные ритмы
Новое исследование португальских ученых показывает, что одно из самых опасных африканских заболеваний – африканский трипаносомоз человека или сонная болезнь – это не просто расстройство сна, обусловленное паразитом в центральной нервной системе. Работа опубликована в журнале Nature Communications.
Эксперименты, проведенные на мышах группой Луизы Фигейреду из Института молекулярной медицины в Лиссабоне, показывают, что сонная болезнь поражает циркадные ритмы, беря под контроль несколько жизненно важных систем организма.
Исследование авторов показывает, что болезнь на самом деле берет под контроль работу генов циркадных ритмов человека, из-за чего и возникают все проблемы. Исследования на мышах показывают, что изменения начинаются сразу же после попадания паразита в кровь, еще до того, как достаточное его количество попадет в мозг.
«Что нам еще нужно выяснить, – это то, что именно заставляет внутренние часы менять свой ход в течение сонной болезни. Это производимые паразитом вещества, или молекулы, выделяемые хозяином в ответ на инфекцию? Знание источника поможет нам лучше понять эту болезнь и блокировать ее», – говорит Фигейреду.
Авторы надеются, что их открытие поможет создать новое лекарство от сонной болезни, поскольку существующие препараты крайне токсичны сами по себе и часто приводят к смерти пациента.